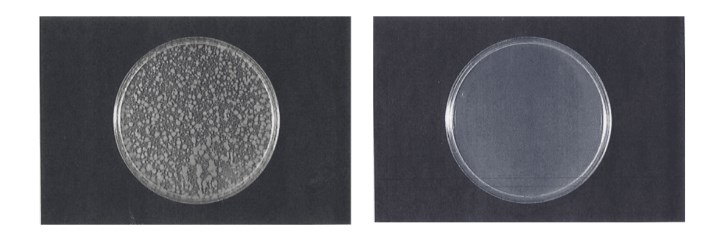

Home Page / Applications / Magical Strong Alkaline Electrolyzed Water Ph13.0
Usually, the types of ionized water are divided according to the pH. According to the different pH, ionized water can be divided into solid acid ionized water (also called acidic oxidation potential water), weakly acidic ionized water, slightly acidic ionized water, and neutral weak alkaline electrolyzed water. Strong alkaline electrolyzed water, as shown below:

Ionized water type
Strong alkaline ionized water will be generated on the cathode side when using the diaphragm method to generate acidic ionized water. Strongly alkaline ionized water, also known as strongly alkaline electrolyzed ionized water, refers to ionized water PH≥ 11.0 (when used for industrial cleaning, its pH ≥ 13.0). Its active ingredient is NaOH/KOH, which contains active ingredients. Hydrogen effectively removes dirt such as lipids and proteins.
The strong alkaline ionized water equipment adopts a diaphragm type electrolytic cell, and the electrolyte is generally K2CO3. The electrolyte can also be NaCl or KCl, produced together with the strong acid electrolyzed water.
The strong alkaline ionized water equipment adopts a diaphragm type electrolytic cell, and the electrolyte is generally K2CO3. The electrolyte can also be NaCl or KCl, produced together with the strong acid ionized water.
Unlike other alkaline waters formed from caustic soda, strong alkaline electrolyzed water does not cause skin irritation or chemical burns. In addition to its bactericidal effect, super alkaline ionized water effectively decomposes oil. It is widely used in cleaning manufacturing products, machinery, parts, and CIP cleaning.
1.Strong alkaline ionized water principle
There are two main ways to make strong alkaline electrolyzed water. The catholyte (the main component of the anolyte is hypochlorous acid) is produced by the electrolysis of sodium chloride solution in a diaphragm electrolytic cell. The other is the diaphragm electrolytic cell. Circulate electrolytic sodium carbonate or potassium carbonate solution.

The strong alkaline ionized water principle (1)

The strong alkaline ionized water principle (2)
2.Strong alkaline ionized water cleaning ability
Saponification: when oil or other fats meet with strong alkali electrolytic water, they will be decomposed. Saponification will make oil pollutants easier to separate.

Emulsification and dispersion: Alkaline electrolyzed water cuts and disperses grease pollutants through emulsification, making it easier to peel off.

Contaminant detachment: Under the action of alkaline electrolyzed water, most pollutant ions have a strong negative potential, and many surfaces to be cleaned also have negative charges, and a repulsive force is generated between the two, which has a strong detoxification effect. Pollution effect. In addition, this repulsive force can also prevent the surface of the object being cleaned from being contaminated again.

Dissolved hydrogen effect: Alkaline electrolyzed water is rich in dissolved hydrogen, which also has a specific impact on pollutant removal.

Micro Clustered character: Water molecules are highly polar molecules. Due to the action of hydrogen bonds, water exists in the form of Clustered water in a liquid state, and this molecular water group will continue to aggregate, disintegrate, and combine (as shown in the following figure). ), under the action of the electric field force formed by the localized ions, the polar water molecules will form molecular clusters around a particular ion. The water of the big water clusters(15-16 clusters) becomes the Micro Clustered water(5-6 clusters) , which has better permeability.

3.Strong alkaline ionized water Bactericidal properties
Because of its high pH, strong alkaline ionized water can hydrolyze the protein and nucleic acid of pathogenic bacteria, destroy the normal metabolic function of bacteria, and make bacteria die. It has a strong bactericidal effect and can kill viruses.
Strong alkaline ionized water (pH12.5) acts as a sterilizing effect for 30s
4.Anti-rust performance of strong alkaline ionized water
Strong alkaline ionized hydrogen molecules supersaturated dissolved in water, REDOX potential is shallow, dissolved oxygen is also very little, so it can prevent metal rust in the liquid to form iron hydroxide film.

5.Strong Alkaline Electrolyzed Water in Daily Chemicals Application
Strong alkaline ionized water is widely used in Japan and China as a multi-functional cleaning solution, mainly used for kitchen oil removal, fruit and vegetable pesticide residue removal, etc.

No. 1 Remove oil dirt

No . 2 Remove pesticide

No . 3 Anti bacteria and Inhibiting bacteria
